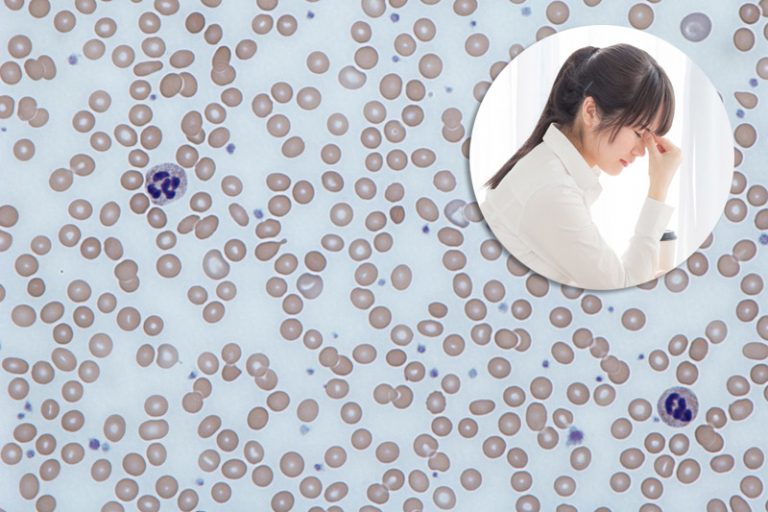
貧血

貧血 | 怠倦氣促是貧血症狀?3分鐘了解甚麼是貧血、成因及治療方法

過去幾年,除了在自己診所睇症,偶然也到一間體檢中心幫手解報告。過程中,我發現不少朋友都對貧血這個情況有所輕忽,尤其是女士們。
實在,貧血對女士來說是十分普遍。始終正常每月都有血液流失,若加上食物中鐵質不足就容易出現貧血。但其實貧血並非一個病,而只是一個身體狀況,背後反映的可以是非常不同的身體問題。當中有些可以只是當成正常,例如輕微的地中海貧血;但有一些則可以是生死尤關,例如血癌、大腸癌等。
82998次閱讀

過去幾年,除了在自己診所睇症,偶然也到一間體檢中心幫手解報告。過程中,我發現不少朋友都對貧血這個情況有所輕忽,尤其是女士們。
實在,貧血對女士來說是十分普遍。始終正常每月都有血液流失,若加上食物中鐵質不足就容易出現貧血。但其實貧血並非一個病,而只是一個身體狀況,背後反映的可以是非常不同的身體問題。當中有些可以只是當成正常,例如輕微的地中海貧血;但有一些則可以是生死尤關,例如血癌、大腸癌等。

簡單來說,血液內的血紅素低於參考範圍就屬於貧血(一般來說男士下限為13.5,女士為11.5)。而跟據血紅素的水平,再為以分為輕度(Hb>9.5g/dl)、中度(Hb 8-9.5g/dl)和嚴重(Hb<8g/dl)。這裡所只的輕度或嚴重是指貧血的情況本身有多大風險引起併發症,而非貧血的病因的嚴重性。

一般來說,輕度分貧血通常沒有臨床病徵。中度或以上的貧血可以引起怠倦、氣促、心悸等病徵。嚴重貧血若沒有適當處理,可以引致心臟衰竭等併發症,甚至對生命構成威脅。
我們可以想像我們的骨髓就是一間負責做血工廠,我們的腎會製造紅血球生成素(erythropoetin),就像訂單一樣指示工廠生產血液,而其中一個產品就是紅血球。紅血球是一種血細胞,內有血紅蛋白(haemoglobin)。製造紅血球有幾種特別原料,包括鐵質、維他命B-12、葉酸(folic acid)等。而我們的DNA(遺傳密碼)就是製作紅血球的籃圖。最後老舊的紅血球會在脾臟被過濾和分解。
血液流失和在這條紅血球生產線上出現任何問題,都可以引致貧血。

貧血的處理包括兩方面:
(一)治療貧血的情況和(二)找出引致貧血的原因並對症下藥。
治療貧血主要考慮貧血的嚴重情度,嚴重貧血一般需要透過輸血去處理,而輕徵至中度的個案則通常在找到病因後才按實際情況處理如服用補充劑。不過若患者的貧血是由慢性腎衰竭導致,則可以注射紅血球生成素治療有病徵的中度貧血和嚴重貧血。
病因方面,醫生會根據整個全血球數(complete blood count/complete blood picture)和患者的病史等去決定下一定的檢驗。
身體檢查發現貧血,不能掉以輕心,一定要確認貧血的成因以對症下藥。
延伸閱讀

